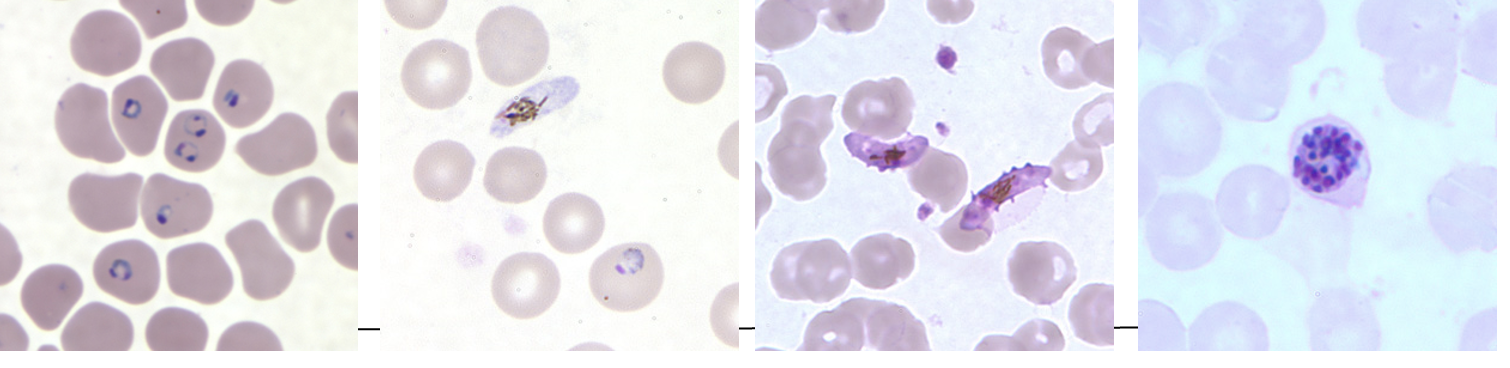
<p><strong>Thick and thin blood smears</strong> (look for <strong>trophozoite "signet rings"</strong>)</p>

38 - Protozoa II
1/41
There's no tags or description
Looks like no tags are added yet.
Name | Mastery | Learn | Test | Matching | Spaced |
|---|
No study sessions yet.
42 Terms
Which Plasmodium species causes the most infections and deaths worldwide?
Plasmodium falciparum
What are the other Plasmodium species that infect humans?
P. vivax
P. ovale
P. malariae
P. knowlesi (zoonotic from macaques, only in Southeast Asia)
What is the vector for malaria?
Anopheles spp. mosquitoes
What are general symptoms of malaria?
Fever
Rigors (shaking chills)
Headache
Nausea/vomiting
Malaise
Back pain (from splenomegaly or kidney damage)
What is the hallmark clinical pattern of malaria?
Recurrent fever cycles with:
Cold stage (chills)
Hot stage (fever, headache, nausea/vomiting)
Sweating stage (sweats, malaise, fever resolves)
What severe complications are specific to P. falciparum infection?
Cerebral malaria
Blackwater fever
What causes cerebral malaria in P. falciparum infection?
A Plasmodial protein expressed on infected RBCs causes them to adhere to vessel walls → capillary plugging
What are symptoms of cerebral malaria?
Altered behavior
Impaired consciousness
Seizures
Coma
What is blackwater fever?
A hemolytic crisis with kidney involvement due to massive RBC lysis and hemoglobin release
What species cause malaria relapse?
Plasmodium vivax and Plasmodium ovale
What stage allows P. vivax and P. ovale to cause relapse?
Hypnozoite stage – a dormant stage in hepatocytes lasting ≥28 days
Describe the relapse mechanism of malaria?
Hypnozoites “awaken” and replicate
Infected hepatocytes rupture → release of merozoites
Merozoites infect RBCs → fever/chills cycles return
What is the gold standard for malaria diagnosis?
Thick and thin blood smears (look for trophozoite "signet rings")
What types of drugs are used to treat malaria?
Quinine-containing compounds, including:
Quinine
Chloroquine
Mefloquine
What must be considered when selecting malaria treatment?
Drug resistance (important consideration in treatment planning)
What is the most common Babesia species infecting humans?
Babesia microti
What is the vector for Babesia microti?
Ixodes scapularis tick (also known as deer tick or blacklegged tick)
Where in the U.S. is Babesia microti most commonly found?
Northeast U.S. (e.g., New England, NY, NJ)
Upper Midwest (e.g., Minnesota)
How is Babesia microti transmitted?
Bite of infected Ixodes tick (usually young nymph stage, size of a poppy seed)
Blood transfusion (contaminated blood)
Vertical transmission (in utero or during delivery from mother to baby)
What is the cellular tropism of Babesia microti?
Red blood cells (RBCs) → leads to hemolytic anemia
How is Babesia infection diagnosed?
Thick and thin blood smears to visualize parasites in RBCs
What forms of Babesia are seen on microscopy?
Trophozoite form = gamete, appears as signet ring
Merozoite form = appears as Maltese cross

What animals are reservoirs for Toxoplasma gondii?
Wild birds and rodents (infect cats)
Cats are definitive hosts (infected by eating infected prey)
How can livestock and produce become contaminated with T. gondii?
Through contact with oocyst-contaminated soil
What tissues can T. gondii oocysts form in?
Skeletal muscle
Myocardium
Brain
Eyes
What are the routes of transmission for T. gondii?
Inhaling/ingesting oocysts (e.g., when changing litter box)
Who is at high risk for severe toxoplasmosis?
Pregnant women
Immunocompromised individuals, especially:
AIDS patients
Those immunosuppressed for cancer or transplant

How is Leishmania transmitted?
Via the sandfly in a human–sandfly–human cycle
What disease does Leishmania tropica cause?
Cutaneous leishmaniasis (skin ulcers)
What disease does Leishmania donovani cause?
Visceral leishmaniasis (kala-azar)
What cells does Leishmania infect, and how does it affect them?
Infects reticuloendothelial system cells (e.g., macrophages)
Alters signaling processes in macrophages
What organs are affected by visceral leishmaniasis?
Liver
Spleen
Bone marrow
What are symptoms of visceral leishmaniasis?
Hepatosplenomegaly
Spiking fevers
Weight loss
Pancytopenia (↓ RBCs, WBCs, platelets)
How is leishmaniasis diagnosed?
Bone marrow macrophages with intracellular amastigotes
Occasionally seen in peripheral macrophages
Serum antibodies may be present in visceral disease

How does cutaneous leishmaniasis usually begin?
A papule develops at the sandfly bite site
What does the papule develop into?
An ulcer with raised edges = VOLCANO SIGN

What are other characteristics of cutaneous lesions?
May be painless or painful
May have enlarged regional lymph nodes (LN)
Heals with crater/pit in skin
What is the key virulence mechanism of Trypanosoma cruzi?
Immune evasion by changing coat proteins
What is the vector for T. cruzi (Chagas Disease)?
Triatomine bug, also known as:
Reduviid bug
“Kissing bug”
How is T. cruzi transmitted?
The bug defecates while feeding
Trypomastigotes in feces enter through bite wound or mucous membranes when the person rubs or scratches
What are the symptoms of acute Chagas Disease?
Often mild
Chagoma – localized swelling at bite site
Romaña sign – unilateral periorbital swelling (classic finding)
How is acute Chagas diagnosed?
Detection of trypomastigotes in blood
Blood smears
Fluorescent staining
Along with clinical presentation
